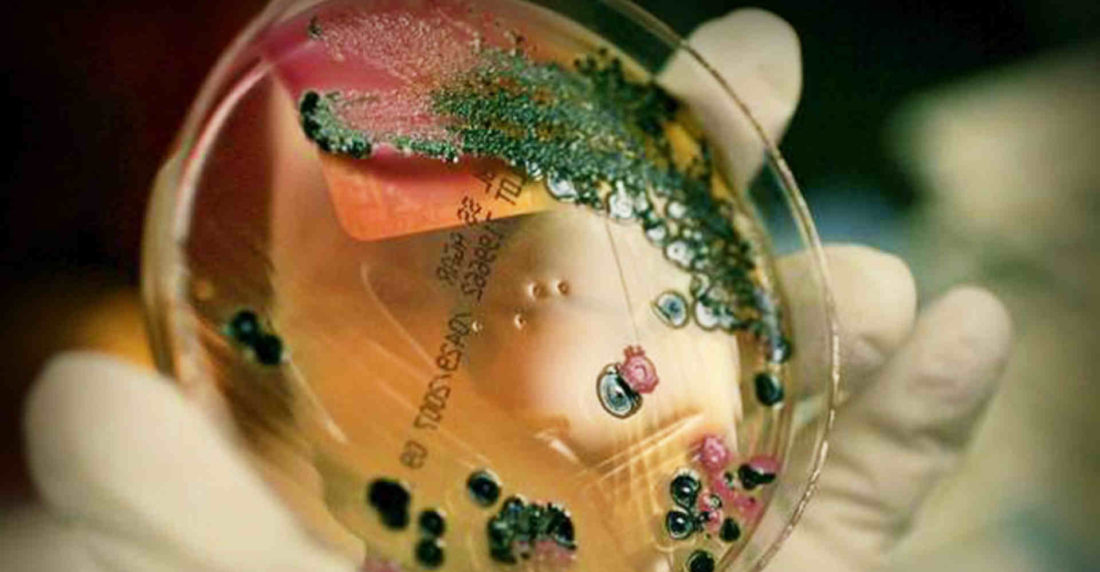

La Salmonella es un género de bacterias que pertenece a la familia Enterobacteriaceae, estos son microbios móviles que producen ácido sulfhídrico (H2S). Ahora, la Salmonelosis es una consecuencia del «animal madre», la Salmonella, una intoxicación por transmisión alimentaria que es más común de lo que se cree; cada año hay decenas de millones de casos en todo el mundo. La mayoría de estos son leves y las complicaciones dependen de factores propios del huésped y de la cepa en cuestión.
Este microbio en forma de vara vive en los intestinos de mamíferos, aves y reptiles, y es generalmente inofensivo. El tipo de Salmonella que es peligroso para la salud de los seres humanos generalmente se contrae por contacto con la carne cruda, huevos crudos,mariscos crudos o productos de origen animal no pasteurizados como la leche y el queso. Estas bacterias también se pueden adquirir cuando hay contacto con tortugas vivas, aves y seres humanos que tienen la bacteria en sus manos; sin embargo, no es una amenaza hasta que se ingiere.
Los síntomas, que aparecen entre las 12 y las 72 horas posteriores a la infección, incluyen diarrea, vómitos, calambres abdominales y fiebre. La intoxicación suele desaparecer por sí sola y sin tratamiento en cinco a siete días. No obstante, si los vómitos y la diarrea son graves y prolongadas, la persona puede deshidratarse y se debe buscar ayuda médica.
En los casos más graves la infección puede extenderse del intestino al torrente sanguíneo y de allí a cualquier parte del cuerpo, pudiendo incluso causar la muerte, como le sucedió al alcalde del municipio Alberto Arvelo Torrealba, Aníbal Chávez. Una minoría de las personas afectadas puede experimentar consecuencias a largo plazo como son: dolor en las articulaciones, irritación en los ojos y dolor al orinar.
Cualquiera puede contraer salmonelosis. Los más vulnerables son los niños menores a 5 años, las personas mayores y los individuos que tengan las defensas bajas; es el caso de quienes están bajo tratamiento para tratar enfermedades como Cáncer o SIDA.
¿Cómo puede prevenirse?
-Cocinar bien el pollo, la carne picada, y los huevos. Evitar comidas que contengan alimentos crudos de origen animal.
-Preparar con especial cuidado las comidas
-Lavar bien frutas y verduras.
-Lavarse bien las manos antes de comer, luego de ir al baño, y luego de tocar alimentos crudos.
-Lavarse bien las manos con agua y jabón luego de tocar animales: reptiles, pollitos, pájaros o cualquier mascota.
¿Cuál es el tratamiento?
En casos graves se necesita rehidratación o antibióticos. Si bien actualmente está controlado, diferentes países han tomado medidas para impedir cualquier riesgo, entre ellas, limitar productos que tengan ingredientes naturales por otros artificiales, como la mayonesa y contacto con animales.